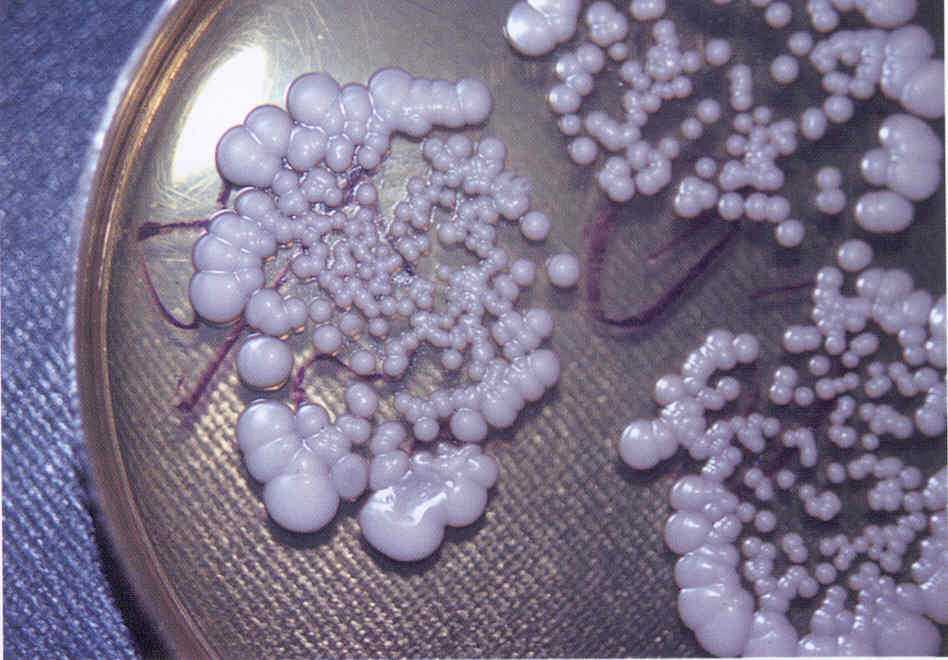

Сбор мокроты
Можно брать экссудат следующего рода:
- материал после ингаляции небулайзером;
- промыванием бронхов специальными растворами;
- мокрота из альвеол;
- получение слизи при бронхоскопии;
- взятие биоптата их трахеи, бронхов или плевры;
- мокрота из бронхов;
- мазки с гортани.
Ёмкости должны соответствовать следующим требованиям:
- делаться из ударопрочного материала;
- иметь хорошую прозрачность для возможности визуальной оценки качества и количества мокроты;
- расплавляться при температуре 40-45 градусов;
- иметь объём не меньше 40-50 мл;
- отверстие должно быть шире 3 см.

Результативность и достоверность исследования мокроты зависит от правильности её сбора, соблюдения рекомендаций, которые должны минимизировать вероятность загрязнения материала. Кроме того, откашливание производится в герметичной комнате, так как данная процедура опасна для всех окружающих.
Что нужно знать при сборе мокроты?
При сборе материала нужно соблюдать ряд правил:
откашливание мокроты во флакон делается до начала химиотерапии;
также его проводят обязательно с утра, до завтрака и приёма препаратов;
при исследовании берут 3 пробы (каждый раз откашливая в новую ёмкость) в течение 3 суток подряд;
материал сразу же отвозят в лабораторию (в течение часа)
В идеале она должна находиться в одном здании с туберкулёзным стационаром;
при невозможности это сделать пробу ставят в холодильник при +4оС, но держать там можно не более 2 суток;
крайне важно следить за целостностью ёмкостей. Нарушение герметичности приводит не только к порче пробы, но и к опасному заражению окружающей среды;
объём одной пробы должен составлять 3-5 мл;
медицинский работник обязательно одевает халат, шапку, медицинскую маску, резиновые перчатки и специальный фартук;
больному нужно откашливать не слюну или слизь из носа и глотки, а именно мокроту из нижних отделов бронхов
Для создания продуктивного кашля можно сделать 2-3 глубоких вдоха;
перед откашливанием рот тщательно промывают водой, чтобы удалить естественную микрофлору и кусочки пищи;
ёмкость держат у самых губ, после откашливания мокроту сразу сплёвывают;
медицинский работник стоит сзади больного, чтобы мокрота не попала на него. Его задача – контролировать правильность сбора материала;
после сбора слизи флаконы сразу герметично запечатывают;
если больному трудно откашливать мокроту, то накануне вечером, а также рано утром перед сбором слизи пациенту даёт отхаркивающие препараты.
Режим сбора материала для лабораторного анализа на туберкулёз легких зависит от стадии развития и лечения заболевания:
- При первом поступлении в течение 3 суток делают по 3 пробы ежедневно.
- Во время лечения ежемесячно собирают 3 пробы за раз.
- На долечивании каждые 2-3 месяца берут 2 пробы мокроты.
Вопрос-ответ: лабораторная диагностика туберкулеза
В Чувашской Республике проходит акция «Белая ромашка», посвященная Всемирному дню борьбы с туберкулезом, которая продлится до 20 апреля. О существовании этого недуга люди знали с древнейших времен. И в настоящее время туберкулез продолжает оставаться ведущей инфекционной болезнью, уносящей жизни людей во всем мире. Для
В распознавании и дифференциальной диагностике туберкулеза, а также в эффективности проводимого лечения очень важную роль играют лабораторные методы исследования. На наиболее распространенные вопросы о лабораторной диагностике туберкулеза отвечает заведующий бактериологической лабораторией Ольга Стебловская.
— Ольга Евгеньевна, расскажите, что такое МБТ?
Это туберкулёзные палочки — Микобактерии туберкулеза (МБТ).
— Где же находят эти туберкулёзные палочки?
При туберкулезе легких Микобактерии туберкулеза (МБТ) чаще всегонаходят в мокроте. Как много туберкулезных палочек выделяет больной и как долго зависит от формы туберкулезного процесса. Часто и много выделяют МБТ больные инфильтративным и фиброзно-кавернозным туберкулезом, особенно, если есть полости распада. Реже и гораздо меньше выделяют МБТ больные очаговым и диссеминированным туберкулезом легких. Если мокроты у больного много, МБТ находят в большем количестве, а в скудной мокроте МБТ встречается реже и в виде единичных экземпляров.
Второе место по эффективности выделения МБТ у больных, не выделяющих мокроту,занимают исследования промывных вод бронхов.
Также можно искать МБТ в плевральной жидкости при плеврите, в моче- при туберкулезе мочеполовых органов, и в других выделениях организма больного.
— Как обнаруживают туберкулёзные палочки в лаборатории?
Частота обнаружения МБТ зависит от способа исследования биоматериала
1. Бактериоскопический метод — поиск МБТ на стекле под микроскопом. Среди бактериоскопических методов больше всего МБТ обнаруживает люминесцентная микроскопия,когда мазок окрашивают светящимися красителями и изучают в люминесцентном микроскопе. Бактериоскопическим методом МБТ обнаруживается чаще при обильном бактериовыделении- 100000 МБТ в 1 мл материала.


2. Бактериологический способ — посев выделений больного на искусственные питательные среды и получение культуры МБТ с последующим изучением ее свойств.По частоте обнаружения МБТ посев материала на плотные или жидкие питательные среды занимает первое место. Для получения культуры МБТ достаточно всего 20-100 микробов в материале от больного.
При бактериологическом способе исследования удается не только выявить туберкулезные палочки, но и подсчитать их количество, а также изучить лекарственную чувствительность к противотуберкулезным препаратам и составить схему лечения больного.
Бактериологический метод (посев материала на специальные среды) обнаружения МБТ очень высокоточный, но имеет существенный недостаток: для получения культуры требуется 4-12 недель.


Применение жидких питательных сред и специального оборудования (бактериологических анализаторов) позволяет определить рост МБТ уже через 5дней.


3. Молекулярно-генетические методы (ПЦР)- поиск в биоматериале генетических маркеров МБТ. Метод ПЦР очень точен, позволяет проводить исследование небольшого количества материала и обнаружить 5-20 клеток МБТ. По оценкам специалистов метод ПЦР превосходит бактериоскопический и бактериологическийметоды, особенно при диагностике внелегочных форм туберкулеза.



В бактериологической лаборатории Республиканского противотуберкулезного диспансера представлен полный спектр методов для диагностики туберкулеза:
— бактериоскопические методы; классический посев и определение лекарственной чувствительности МБТ на плотных средах;
— ускоренная методика на жидких средах с применением бактериологического анализатора BACTECMGIT 960;
— молекулярно-генетические методики: ПЦР В РЕАЛЬНОМ ВРЕМЕНИ и методика HAINTEST.
Бактериоскопия и посев мокроты
Для бактериоскопического исследования предварительно готовят препарат. Вначале растирают комок мокроты между двумя предметными стёклами; затем высохший мазок фиксируют над пламенем горелки и окрашивают: для поисков микобактерий туберкулёза по Цилю-Нильсену, в других случаях — по Грамму.
Чувствительность бактериоскопического метода напрямую зависит от кратности обследования пациента. Например, согласно исследованиям, однократный анализ мокроты на микобактерии туберкулёза имеет чувствительность 80-83%, двукратный анализ мокроты (в течение двух дней) — на 90-93% больше и при исследовании трёх проб мокроты (в течение трёх дней) — 95-98%. Таким образом, при подозрении на туберкулез органов дыхания необходимо исследовать не менее трёх проб мокроты.
Отрицательный результат микроскопического исследования не исключает диагноз той или иной инфекции, так как мокрота пациента может содержать меньше микробов, чем может выявить микроскопическое исследование.
Когда бактериоскопическое исследование не обнаруживает предполагаемого возбудителя, прибегают к посеву мокроты на питательные среды. Посев мокроты производят не позднее 2-х часов после сбора. Если подозревается туберкулёз, то сбор мокроты осуществляют в течение 3-х последовательных дней.
Бактериологическое исследование позволяет идентифицировать вид микробов и определять их антибиотикочувствительность.
Обычно у здоровых лиц в мокроте при посеве выявляются альфа-гемолитический стрептококк, Neisseria spp., дифтероиды. Обнаружение лишь нормальной микрофлоры ещё не означает отсутствие инфекции. Результат посева следует интерпретировать с учётом клинической картины и общего состояния пациента.
Критерием этиологической значимости возбудителя будет выявления микроба в концентрации 106
в 1 мл и выше. Но к выявлению микобактерий туберкулёза в любом количестве следует отнестись со всей серьёзностью.
Исследование мочи, кала, цереброспинальной и плевральной жидкости на МБТ
В клинической практике МБТ нередко приходится проявлять в моче, кале, цереброспинальной и плевральной жидкости. Исследование мочи на МБТ проводят в тех случаях, когда в ходе исследования осадка в каждом поле зрения оказывается не менее 15 лейкоцитов.
Для выявления МБТ мочу многократно центрифугируют, наслаивая каждый раз новые порции с осадка мочи на предметное стекло. Мазок окрашивают по методу Диля-Нильсена. Выявление микобактерий туберкулеза в моче свидетельствует о наличии туберкулеза почек.
Для исследования мочи по методу флотации дают ей постоять, затем 20-30 мл осадка обрабатывают, как обычно, без подогрева на водяной бане. Отсутствие МБТ в гнойной мочи и это не исключает наличия туберкулеза почек. В таких случаях нужно или делать ее посев на питательные среды, или применять биологический метод исследования.
Исследование кала на МБТ следует проводить в случаях подозрения на туберкулез кишок. При этом надо помнить, что у больных, выделяющих МБТ и частично заглатывают мокроту, МБТ можно выявить при исследовании кала и за непораженных кишок, поскольку микобактерии туберкулеза устойчивы и не всегда погибают под воздействием пищеварительных соков. В кале больных туберкулезом кишок часто оказывается слизь, кровь и примеси гноя.
Обнаружение МБТ в цереброспинальной жидкости нередко имеет решающее значение в диагностике туберкулезного менингита. Однако бактериоскопическим методом выявить МБТ удается только в 10-20% больных туберкулезный менингит. Исследование проводится по следующей методике. Пробирку с цереброспинальной жидкостью ставят на 8-10 часов в прохладном месте. Если в ней образуется нежная фибринная пленка (она состоит из клеток и МБТ), ее наносят на предметное стекло и готовят препарат по методу Циля-Нильсена. В случаях, когда пленка не образуется, препарат готовят из осадка после центрифугирования.
Для выявления МБТ в плевральном экссудате, пунктатах и выделении из свищей готовят препарат так же, как и при исследовании мокроты.
Бактериологическое исследование состоит из посева материала на питательные среды и дифференциации культуры МБТ от кислотоустойчивых сапрофитов. Этим методом можно обнаружить микобактерии туберкулеза, когда в 1 мл материала находится 20-100 микробных клеток. Пробирки со средой помещают в термостат при температуре 37 ° С. Первые колонии микобактерий могут появиться на 18-30-й день, а иногда — через 2-3 месяца. Бактериологическое исследование проводят одновременно с бактериоскопическим трижды.
Посев исследуемого материала производится на специальные среды после предварительной обработки. Чаще всего используют такие среды: Левенштейна-Йенсена, Финна-2, Миддлбрука, Огава и др., которые содержат вещества, задерживающие рост посторонних микроорганизмов. Предварительная обработка патологического материала заключается в уничтожении сопроводительной бактериальной флоры. Посев материала из бронхов, а также посев мочи делают из центрифугата или осадка. При этом мочу, если она не загрязнена, можно не обрабатывать.
Предварительная обработка биологического материала
Для подготовки к посеву мокроты, плеврального экссудата, цереброспинальной жидкости существует несколько методов предварительной обработки.
Метод Мазура заключается в обработке патологического материала 3-4 мл 2% раствором серной кислоты в стерильной пробирке. Пробирку встряхивают в течение 3 мин., после чего материал стерильной платиновой петлей наносят на яичные среды.
Метод Петрова: мокроты обрабатывается 4% раствором гидроксида натрия в течение 15 мин., А затем центрифугируется.
Плюсы и минусы метода
Польза исследования мокроты при пневмонии очевидна. Метод диагностики позволяет определить характер заболевания (бактериальный, вирусный или грибковый), выявить основной возбудитель, играющий значительную роль в дальнейшем лечении.
Однако анализ мокроты имеет ряд серьезных недостатков:
Высокая степень погрешности результатов — даже при соблюдении всех правил сбора мокроты погрешность результата высока, то есть он может быть ложноположительным или ложноотрицательным
Это связано с большой вероятностью проникновения микрофлоры полости рта в мокроту.
Ограничения на транспортировку — важно, чтобы биоматериал прибыл в лабораторию как можно скорее (максимальное время транспортировки — 2 часа). Чем больше время транспортировки, тем менее надежен тест.
Для увеличения вероятности «правильного» анализа мокроты и повышения точности конечного результата рекомендуется собрать биоматериал в 2 контейнера. Выполнение теста позволит сравнить результаты и повысить точность диагностики.
Список использованной литературы
1. Лабораторные и инструментальные исследования в диагностике: Справочник / Пер. с англ. В.Ю. Халатова; под. ред. В.Н. Титова. — М.: ГЭОТАР-МЕД, 2004. — 960 с.
2. Kincaid-Smith P., Larkins R., Whelan G. Problems in clinical medicine. — Sydney: MacLennan and Petty, 1990, 105-108.
3. Лабораторные методы исследования в клинике: Справочник. Под ред. проф. Меньшикова В.В. — М.: «Медицина», 1987. — 368 с.
4. Пропедевтика внутренних болезней. Под ред. В.Х. Василенко, А.Л. Гребнёва. — М.: «Медицина», 1982. — 640 с.
5. Справочник по клиническим лабораторным методам исследования. Под ред. Е.А. Кост. — «Медицина», 1975 — 383 с.
..
307
308
309 ..
Мокрота – причины
Перепроизводство слизи провоцируется воспалительными, инфекционными и экологическими факторами:
- Заболевания носоглотки. Выделения на задней стенке горла, стекающие из носа и пазух — симптом простуды и респираторной инфекции. Мокрота может быть следствием ринита, синусита, вирусного эпиглоттита, трахеита и ларингита.
- Заболевания легких и бронхов. Мокрота образуется при бронхите, воспалении и и раке легких, туберкулезе и др. патологиях.
- Аллергия. У аллергиков наблюдается чрезмерное выделение мокроты в горле.
- Влияние стероидов. Астматики используют для лечения стероидные ингаляционные препараты. Побочный эффект этой терапии — повышенная секреция слизи, поэтому у больных возникает ощущение мокроты в горле.
- Влияние никотина. В случае с курильщиками организм защищается от вредных веществ и вырабатывает секрецию, увлажняющую горло.
- Заболевания ЖКТ. Мокрота в горле, возникающая после еды — следствие гастроэзофагеального рефлюкса. Причина симптома — выбрасывание кислоты из желудка в пищевод.
- Психосоматические расстройства (невротическая мокрота). Проявляется ощущением наличия в горле инородного тела размером с грецкий орех. Это конверсионное расстройство, в основе которого лежит невроз.
Другие причины возникновения мокроты в горле:
- напряжение на вокальные связки;
- гормональные изменения — гипотиреоз, болезнь Хашимото;
- врожденные дефекты — искривление носовой перегородки;
- аутоиммунные заболевания;
- вдыхание загрязненного воздуха.
При наличии хронической мокроты любого типа необходимо обратиться к специалисту.
Культуральное исследование
Проводят посев материала на стандартную среду Сабуро, часто с добавками антибиотиков. В диагностике дерматофитных инфекций принято добавлять в среду Сабуро циклогексимид, подавляющий рост грибов-контаминантов, попадающих из воздуха. Существуют готовые коммерческие среды с добавками антибиотиков и циклогексимида. Следует помнить, что многие плесневые грибы-недерматофиты и некоторые виды Candida не растут на среде с циклогексимидом, поэтому рекомендуется делать посев на среду Сабуро с циклогексимидом и на среду без него. Идентификацию видов обычно проводят при микроскопическом исследовании выросшей культуры или путем пересева на селективные среды (рис. 2-15).
Рис. 2. Культура гриба Т. rubrum, выделенного из пораженных ногтей. Получена на среде Сабуро (слева) и кукурузном агаре (справа)
Рис. 3. Культура гриба Т. mentagrophytes var. interdigitale, выделенного из пораженных ногтей. Получена на среде Сабуро.
Рис. 4. Культура гриба Candida albicans. Получена на среде Сабуро. 
Рис. 5. Культура гриба Torulopsis glabrata, выделенного из пораженных ногтей. Получена на среде Сабуро.
Рис. 6. Культура гриба Ulocladium sp., выделенного из пораженных ногтей.
Рис. 7. Микроморфология Acremonium sp., выделенного из пораженных ногтей. 
Рис. 8. Микроморфология Fusarium sp., вьщеленного из пораженных ногтей.
Рис. 9. Микроморфология Scopulariopsis sp., выделенного из пораженных ногтей.
Рис. 10. Микроморфология Candida albicans, выделенного из пораженных ногтей.
Рис. 11. Микроморфология Altemaria sp., выделенного из пораженных ногтей.
Рис. 12. Микроморфология Aspergillus sp., выделенного из пораженных ногтей.
Рис. 13. Микроморфология Ulocladium sp , выделенного из пораженных ногтей.
Рис. 14. Микроморфология Chaetomium sp., выделенного из пораженных ногтей. 
Рис 15. Панель питательных фед для идентификации дерматофитов (слева — культура Т rubrum, справа — Т mentagrophytes var. mterdigitale). Слева направо: среда Сабуро, среда Бакстера, среда Христенсена, кукурузный агар
Следует учесть, что некоторые плесневые грибы, в том числе дерматофиты, в культуре вырастают медленно, за 2-3 нед.
Даже при соблюдении всех правил сбора материала, при хорошем оборудовании лаборатории и высокой квалификации ее персонала число положительных результатов культурального исследования очень невелико.
По данным зарубежной литературы, процент положительных исследований не превышает 50.
Процент положительных результатов в лучших отечественных лабораториях едва достигает 30.
Таким образом, в 2 из каждых 3 случаев онихомикоза его этиологию установить не удается.
Симптомы мокроты в горле и дыхательных путях
Наиболее интенсивное отхаркивание мокроты происходит сразу после пробуждения, поэтому многие люди жалуются на утреннее чувство дискомфорта. Отхаркивание сопровождается болью, ощущением “комка” в горле и ограничением голосовых способностей — изменения в звучании и охриплость голоса.
Симптомы мокроты в горле:
- ощущение щекотки в горле;
- рвотный рефлекс;
- раздражение слизистой оболочки;
- измененный голос;
- хрипы.
Длительность выделений в горле и дыхательных путях зависит от причины. При бактериальных инфекциях мокрота может выделяться до 2-х недель (если не используется антибиотик), при вирусных – до 3-х недель. Хроническим симптом считается, если от него невозможно избавиться в течение более 3-4-х недель.
Мокрота в горле и дыхательных путях может сопровождаться лихорадкой, ушными болями, чувством слабости, как при простуде, ощущением расчесывания в горле, болями в груди. Человек, которого беспокоит охриплость или мокрота в горле, часто пытается избавиться от секрета, что сопровождается характерным звуком.
Этапы проведения
Это принцип анализа в лабораторных условиях
Во время обследования специалист обращает внимание на такие характерные особенности, как цвет мокроты, ее консистенцию и запах. После того, как визуальная оценка биоматериала завершена и все важные характеристики зарегистрированы, проводится 3 этапа диагностики:
Микроскопия — обнаружение бактериальных агентов в анализе мокроты
На этом этапе также проводится оценка по Грамму.
Микробиологическое обследование — уделяется внимание выделению патогенного микроорганизма, вызвавшего развитие пневмонии. Определяется чувствительность микроорганизма к определенному типу антибактериальных средств.
Биохимия — это окончательный анализ, при котором в биоматериале выявляется наличие пятен крови, белка, различных ферментов, желчного пигмента и активных биологических веществ.
Медицинский центр Первый Доктор на Киевской
Сеть клиник. Основной деятельностью клиники является оказание медицинских услуг как в клиниках, так и на дому, а именно: анализы, гастроэнтерология, гинекология, гомеопатия, дерматология, кардиология, ЛОР, маммология, неврология, офтальмология, стоматология, травматология, урология, флебология, хирургия, эндокринология и др. В клинике на Киевской проводят ряд диагностик: УЗИ, 3D УЗИ, 4D УЗИ, биопсию, гастроскопию, ДС (дуплексное сканирование), кардиотокографию (КТГ), суточное ЭКГ мониторирование (по Холтеру), суточное мониторирование АД, ЭКГ-проба с дозированной физической нагрузкой (велоэргометрия или тредмил-тест), кольпоскопию, ЭФГДС, ЭКГ, ЭХОКГ.
Показатели анализа крови при пневмонии
Пневмония, или воспаление легких, это инфекционное заболевание, которое характеризуется поражением различных отделов легких. Анализ крови при пневмонии необходимо сдать сразу же после обнаружения этого заболевания.

Клинически эту болезнь можно разделить на:
- очаговую – пневмония, затрагивающая отдельные участки легких (альвеолы и бронхи);
- крупозную – при которой в патологический процесс вовлекается целая доля легкого.
Воспаление легких – одно из самых распространенных заболеваний органов дыхания.
Исследования показывают, что из 100000 населения ей болеют около 400 человек.
Для постановки диагноза и назначения правильного лечения необходима тщательная диагностика. Одним из самых показательных этапов диагностики данного заболевания являются общие, клинические методы обследования. К ним относится осмотр и составление анамнеза пациента. Кроме общего объективного осмотра, для диагноза понадобятся данные лабораторных исследований
Анализы при этой болезни должны обязательно включать общие и биохимический анализы крови, мочи и анализ мокроты. Самое важное и обязательное лабораторное исследование – это общий анализ крови. Иногда при воспалительном процессе анализы крови находятся в норме
Отсутствие реакции крови при этой болезни говорит о том, что ослаблена иммунная система, которая не может адекватно реагировать на воспаление.
Результаты анализов
В анализе крови при острой очаговой стадии наблюдается умеренный нейтрофильный лейкоцитоз, а при острой долевой пневмонии тяжелой степени виден значительный лейкоцитоз. Лейкоцитарная формула – это процентное соотношение различных видов лейкоцитов.
- Миелоциты.
- Метамиелоциты.
- Нейтрофилы палочкоядерные: 1-5 %
- Нейтрофилы сегментоядерные: 40-70%.
- Лимфоциты: 20-45%.
- Моноциты: 3-8%.
- Эозинофилы: 1-5%.
- Базофилы: 0-1%.
- Плазмоциты.
Типы лейкоцитарной формулы
При различных заболеваниях в организме человека может наблюдаться 3 основных типа изменения лейкоцитарной формулы:
- Сдвиг лейкоцитарной формулы влево (появляются миелоциты и метамиелоциты).
- Сдвиг лейкоцитарной формулы влево с омоложением (появляются миелоциты, метамиелоциты, промиелоциты, миелобласты и эритробласты).
- Сдвиг лейкоцитарной формулы вправо (уменьшается количество палочкоядерных нейтрофилов в сочетании с наличием гиперсегментированных ядер нейтрофилов).
Еще одним из важных показателей воспаления является СОЭ (скорость оседания эритроцитов). В норме скорость оседания эритроцитов у мужчин 1-10 мм за один час, у женщин – 2-15 мм за один час. При острой очаговой пневмонии СОЭ увеличивается умеренно, но вот при заболевании долевого вида может наблюдаться резкое увеличение СОЭ до 50-60 мм за один час.
Также для диагностики болезни проводится биохимический анализ крови
В этом случае внимание обращают на наличие фибриногена и С-реактивного белка. Норма фибриногена в организме у взрослого человека держится в границах от 2 до 4 г на литр, а норма С-реактивного белка составляет 5 мг/л
Повышение количества фибриногена и С-реактивного белка является показателем воспаления в организме. Так, при острой пневмонии наблюдается увеличение уровня фибриногена и С-реактивного белка, а также сиаловых кислот.
При хронической пневмонии лабораторные показатели могут меняться. В фазе ремиссии, то есть в период ослабления болезни, самочувствие пациента удовлетворительное, поэтому лабораторные показатели могут не проявляться, так как отсутствует воспалительный процесс. Если лабораторные показатели и проявляются, то они характеризуются незначительным увеличением СОЭ, также умеренным лейкоцитозом со сдвигом формулы влево. Еще присутствует увеличение фибриногена и альфа-2- и гаммаглобулинов.
Одним из не менее важных исследований является исследование газового состава артериальной крови. При тяжелом течении болезни, вследствие расстройства дыхания, развивается дыхательная недостаточность, поэтому при исследовании газового состава наблюдается гипоксемия (уменьшение содержания кислорода в крови) и гиперкапния (увеличение содержания углекислого газа). При этом исследовании решается вопрос о назначении оксигенотерапии для устранения кислородной недостаточности.
respiratoria.ru>
Клинические анализы
- РАСШИФРОВКА
- ГЕМАТОЛОГИЯ
- ОБЩАЯ КЛИНИКА
-
· Общеклинический анализ мочи
· Суточное количество
· Относительная плотность
· Реакция мочи pH
· Белок мочи
· Сахар, кетоновые тела
· Вещества азотистого обмена
· Мочевой осадок
· Неорганизованный осадок
· Исследование функции почек
· Мочевые камни
· Стаканные пробы
· Исследование кала
· Исследование желудка
· Исследование желчи
· Исследование мокроты
· Исследование спинномозговой жидкости
· Исследование жидкостей серозных полостей:
· · Плевральная полость и перикард
· · Брюшная полость
· · Суставная жидкость
· · Жидкость из кисты - ГЕМОСТАЗ
- БИОХИМИЯ
- ЦИТОЛОГИЯ
- ГЕМОГРАММА
Какие болезни диагностируются с помощью анализа мокроты?
Анализ мокроты — ключевой этап диагностики целого ряда дыхательных патологий. Рассмотрим подробнее эти болезни.
-
Острый бронхит. Мокрота начинает выделяться на первых стадиях болезни. Вначале она слизистая и вязкая, но постепенно приобретает слизисто-гнойный характер. Постепенно растет и количество отделяемого материала. Под микроскопом можно обнаружить лейкоциты, много эпителиальных клеток, одиночные эритроциты.
-
Хронический бронхит. Пациенты с хроническим бронхитом отмечают регулярное отхаркивание большого количества мокроты слизисто-гнойного характера. Изредка встречаются прожилки крови, особенно после интенсивного кашля. В мокроте появляются альвеолярные макрофаги, фибринозные слепки дыхательных путей, а также представители флоры.
-
Астма. Мокрота при астме слизистая и вязкая, имеет стекловидный характер. Наблюдаются спиральные элементы Куршмана и кристаллические фрагменты Шарко-Лейдена, эозинофилы.
-
Бронхоэктазы. Для данной патологии характерно большое количество мокроты, которое может достигать 1 литра. Отделяемое имеет грязный, серо-зеленый оттенок. Если оставить мокроты в посуде на время, она расслоится на несколько видов: слизь, гной и серозная жидкость. Наблюдаются пробки Дитриха, значительное количество лейкоцитов, биохимические примеси.
-
Пневмония. Характерная мокрота продуцируется при крупозной пневмонии. Она имеет вязкую консистенцию, ржавый цвет, выделяется в небольшом количестве. С развитием болезни увеличивается её количество, приобретается слизисто-гнойный характер. Из примесей наблюдается фибрин, измененные эритроциты. Постепенно, эритроцитов становится меньше, повышается количество лейкоцитов.
-
Абсцесс легкого. Мокрота двухслойная, содержит большое количество гноя и примеси слизи. Микроскопическое исследование позволяет обнаружить лейкоциты, волокна тканей, элементы жирных кислот, гематоидин и холестерин. Бактериологический анализ позволяет оценить характер флоры.
-
Туберкулез. Мокрота продуцируется при кавернозной форме болезни. Это сопровождается гнойным отделяемым, с примесями крови и слизи. Микроскопия позволяет определить наличие линз оха, волокон, кристаллов кислот. Если наблюдаются обызвествленные участки, это говорит о распаде старого туберкулезного очага.
-
Злокачественная опухоль. Появление мокроты наблюдается при распаде. Она содержит участки тканей, волокна, кровь, атипичные клетки. Характер — кровянистый, слизистый.
Исследование клеточного состава, химических и физических свойств мокроты
Мокрота — секрет, образующийся в бронхах, трахеи, легких, выделяющийся при кашле и отхаркивании. В норме на поверхности бронхом и трахеи образуется секрет (количество которого достигает 100 мл в день), который обычно сглатывается. Этот секрет выполняет важную физиологическую функцию. Помимо слизи в нем содержаться различные вещества и клетки: иммуноглобулины класса IgA и IgG; молекулы, обладающие бактерицидным действием; ингибиторы протеаз, а также макрофаги. Все эти компоненты, вместе с мерцательным эпителием трахеи, эпителия бронхов выполняют защитные действия от механических влияний пыли и действия патогенных возбудителей. Большое количество мелких частиц, распыленных в воздухе и микроорганизмы прикрепляются к поверхности глотки, трахеи, крупных бронхов, а после проглатывания нейтрализуются и выводятся из организма. При возникновении воспалительных реакций в дыхательной системе, которые часто обусловлены различными инфекционными заболеваниями, количество выделяемой слизи многократно увеличивается. Выделяемая при инфекционной патологии слизь отхаркивается в виде мокроты. Следует сказать, что в ряде случаев повышенное отделение мокроты происходит и без инфекционного процесса — курение, опухоль бронхов (кашель с обильным выделением слизистой и гнойной мокроты), профессиональные заболевания (силикоз — сухой кашель с отделением небольшого объема вязкой мокроты). Общеклиническое исследование мокроты представляется собой изучение физических и химических ее свойств, а также клеточного состава при помощи светового микроскопа.
Источники
- Calderwood CJ., Wilson JP., Fielding KL., Harris RC., Karat AS., Mansukhani R., Falconer J., Bergstrom M., Johnson SM., McCreesh N., Monk EJM., Odayar J., Scott PJ., Stokes SA., Theodorou H., Moore DAJ. Dynamics of sputum conversion during effective tuberculosis treatment: A systematic review and meta-analysis. // PLoS Med — 2021 — Vol18 — N4 — p.e1003566; PMID:33901173
- Gannon AD., Darch SE. Tools for the Real-Time Assessment of a Pseudomonas aeruginosa Infection Model. // J Vis Exp — 2021 — Vol — N170 — p.; PMID:33900293
- Liu Y., Zhang L., Li HL., Liang BM., Wang J., Zhang X., Chen ZH., Zhang HP., Xie M., Wang L., Wang G., Oliver BG. Small Airway Dysfunction in Asthma Is Associated with Perceived Respiratory Symptoms, Non-Type 2 Airway Inflammation, and Poor Responses to Therapy. // Respiration — 2021 — Vol — NNULL — p.1-13; PMID:33895739
- Badi YE., Pavel AB., Pavlidis S., Riley JH., Bates S., Kermani NZ., Knowles R., Kolmert J., Wheelock CE., Worsley S., Uddin M., Alving K., Bakke PS., Behndig A., Caruso M., Chanez P., Fleming LJ., Fowler SJ., Frey U., Howarth P., Horváth I., Krug N., Maitland-van der Zee AH., Montuschi P., Roberts G., Sanak M., Shaw DE., Singer F., Sterk PJ., Djukanovic R., Dahlen SE., Guo YK., Chung KF., Guttman-Yassky E., Adcock IM. Mapping atopic dermatitis and anti-IL-22 response signatures to Type 2-low severe neutrophilic asthma. // J Allergy Clin Immunol — 2021 — Vol — NNULL — p.; PMID:33891981
- Xu C., Zhang W., Wang X., Li Z., Guan G., Wang S., Fan N., Guo Y., Rao W., Wang J., Zheng T., Zang Y. Correlation analysis of pleural effusion and lung infection after liver transplantation. // Minerva Surg — 2021 — Vol — NNULL — p.; PMID:33890441
- Zhang X., Pang L., Lv X., Zhang H. Risk factors for bronchiectasis in patients with chronic obstructive pulmonary disease: a systematic review and meta-analysis. // Clinics (Sao Paulo) — 2021 — Vol76 — NNULL — p.e2420; PMID:33886788
- Velen K., Podewils LJ., Shah NS., Lewis JJ., Dinake T., Churchyard GJ., Reichler M., Charalambous S. Performance of GeneXpert MTB/RIF for Diagnosing Tuberculosis Among Symptomatic Household Contacts of Index Patients in South Africa. // Open Forum Infect Dis — 2021 — Vol8 — N4 — p.ofab025; PMID:33884274
- Feng JN., Gao L., Sun YX., Yang JC., Deng SW., Sun F., Zhan SY. [Accuracy of Xpert MTB/RIF for the detection of tuberculosis and rifampicin-resistance tuberculosis in China: A systematic review and meta-analysis]. // Beijing Da Xue Xue Bao Yi Xue Ban — 2020 — Vol53 — N2 — p.320-326; PMID:33879905
- Hu SY., Long F., Long L., Huang WT., Fu P., Dong HB., Gan JF., Huang ZH. . // Zhonghua Yi Xue Za Zhi — 2021 — Vol101 — N15 — p.1071-1076; PMID:33878834
- McEvoy NL., Clarke JL., Mc Elvaney OJ., Mc Elvaney OF., Boland F., Hyland D., Geoghegan P., Donnelly K., Friel O., Cullen A., Collins AM., Fraughen D., Martin-Loeches I., Hennessy M., Laffey JG., Mc Elvaney NG., Curley GF. A randomised, double-blind, placebo-controlled, pilot trial of intravenous plasma purified alpha-1 antitrypsin for SARS-CoV-2-induced Acute Respiratory Distress Syndrome: a structured summary of a study protocol for a randomised, controlled trial. // Trials — 2021 — Vol22 — N1 — p.288; PMID:33874981
Виды исследования мокроты
Различают следующие виды исследования мокроты:
- Макроскопическое
- Микроскопическое
- Микробиологическое
- Химическое.
Макроскопический анализ позволяет оценить общие свойства и характер мокроты. Оценивается количество мокроты, её консистенция, цвет, запах. Также, изучаются примеси, их характер и количество, различные волокна. Можно определить гной, слизистые частицы, серозную жидкость, элементы гнилостного процесса или распада тканей, кровь, волокна фибрина. Данные элементы могут отсутствовать, встречаться по одному или в комбинациях друг с другом.
Микроскопический анализ дает более точной представление о составе мокроты. Увеличение позволяет определить наличие клеток, элементов тканей. Это могут быть следы эпителия, лейкоциты, эозинофилы, эритроциты.
Бактериологическое исследование помогает подтвердить или исключить наличие микроорганизмов в мокроте. Это могут быть бактерии, грибок, паразиты. Проводится также анализ на чувствительность к антибактериальной терапии, что делает лечение более эффективным, сокращает его сроки и исключает неправильную тактику ведения пациента.
Химический анализ мокроты менее информативен. Проводится реакция на гемосидерин, что позволяет говорить о примеси крови. Также, оценивает кислотность биоматериала.






























